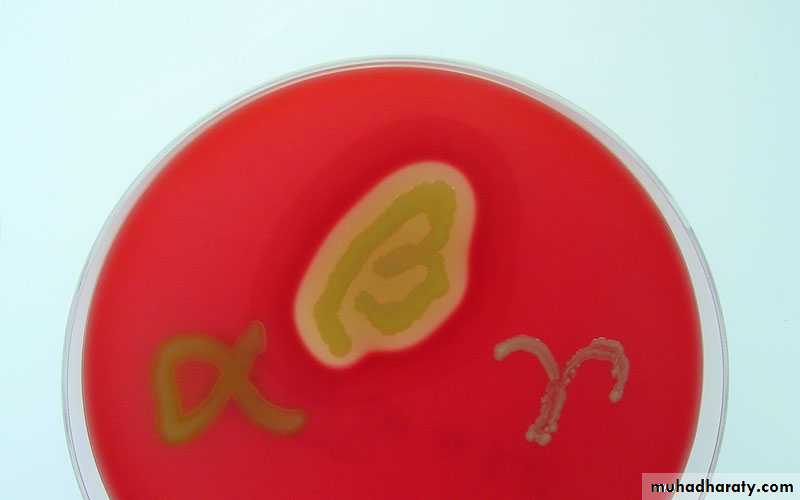

بسم الله الرحمن الرحيم
The Staphylococci
• The staphylococci are G+ spherical cells, usually arranged in grapelike irregular clusters.
• They grow on many types of media and are active metabolically, fermenting carbohydrates and producing pigments that vary from white to deep yellow.
• Some are members of the normal microbiota of the skin and mucous membranes of humans; others cause suppuration, abscess formation, a variety of pyogenic infections, and even fatal septicemia.
• The genus Staphylococcus has at least 45 species. The four most frequently species of clinical importance are Staphylococcus aureus, Staphylococcus epidermidis, Staphylococcus lugdunensis, and Staphylococcus saprophyticus.
• S aureus is coagulase positive, which differentiates it from the other species. S aureus is a major pathogen for humans.
• The coagulase-negative staphylococci (CoNS) are normal human normal microbiota and sometimes cause infection, especially in very young, old, and immunocompromised patients.
• Approximately 75% of these infections caused by coagulase-negative staphylococci are caused by S epidermidis; S saprophyticus is a relatively common cause of urinary tract infections in young women, although it rarely causes infections in hospitalized patients.
Morphology and Identification
Culture• Staphylococci grow readily on most bacteriologic media under aerobic or microaerophilic conditions.
• They grow most rapidly at 37°C but form pigment best at room temperature (20–25°C). Colonies on solid media are round, smooth, raised, and glistening. S aureus usually forms gray to deep golden yellow colonies.
• S. epidermidis colonies usually are gray to white on primary isolation; many colonies develop pigment only upon prolonged incubation.
Growth Characteristics
1-The staphylococci produce catalase, which differentiates them from the streptococci.2-Staphylococci slowly ferment many carbohydrates, producing lactic acid but not gas.
3-Staphylococci are relatively resistant to drying, heat (withstand 50°C for 30 minutes), and 10% NaCl, but are inhibited by certain chemicals.4-Staphylococci are variably susceptible to many antimicrobial drugs. Resistance is caused by several mechanisms:
1. β-Lactamase production is common, is under plasmid control, and makes the organisms resistant to many penicillins (penicillin G, ampicillin, ticarcillin, piperacillin).
2. Resistance to nafcillin (and to methicillin and oxacillin) is independent of β-lactamase production. Resistance to nafcillin is encoded and regulated by a sequence of genes found in a region of the chromosome called the staphylococcal cassette chromosome mec (SCCmec). The mecA and newly described mecC genes on this locus encode a penicillin-binding protein (PBP2a) that is responsible for the resistance, and these strains called methicillin resistant S. aureus (MRSA).
3. In the United States, S aureus and S lugdunensis are considered to be susceptible to vancomycin. Strains of S aureus with intermediate susceptibility to vancomycin have been isolated in Japan, and the United States. These are often known as vancomycin-intermediate S aureus (VISA). They generally have been isolated from patients with complex infections who have received prolonged vancomycin therapy. The mechanism of resistance is associated with increased cell wall synthesis and alterations in the cell wall and is not caused by the van genes found in enterococci. S aureus strains of intermediate susceptibility to vancomycin usually are nafcillin resistant.
4. Since 2002, several isolates of vancomycin-resistant S aureus (VRSA) strains (MICs ≥ 16 μg/mL) were isolated from patients in the United States. The isolates contained the vancomycin resistance gene vanA likely derived from enterococci and the nafcillin resistance gene mecA. Both of the initial VRSA strains were susceptible to other antibiotics. Vancomycin resistance in S. aureus is of major concern worldwide.
5. Plasmid-mediated resistance to tetracyclines, erythromycins, aminoglycosides, and other drugs is frequent in staphylococci.
6. “Tolerance” implies that staphylococci are inhibited by a drug but not killed. Patients with endocarditis caused by a tolerant S aureus may have a prolonged clinical course compared with patients who have endocarditis caused by a fully susceptible S aureus. Tolerance can at times be attributed to lack of activation of autolytic enzymes in the cell wall.
Antigenic Structure
• S aureus has amazing adaptive capacity.• S aureus has acquired many mobile genetic elements (insertion sequences, transposons,) that determine both pathogenicity and antimicrobial resistance. Staphylococci contain antigenic polysaccharides and proteins as well as other substances important in cell wall structure.
• Peptidoglycan,
• Teichoic acids,
• Most S aureus strains of clinical importance have polysaccharide capsules.
• Cell wall virulence factors:
• Protein A is a major component of the S. aureus cell wall. It binds to the Fc moiety of IgG, exerting an antiopsonin (and therefore strongly antiphagocytic) effect.• Fibronectin-binding protein (FnBP) and other staphylococcal surface proteins promote binding to mucosal cells and tissue matrices.
Enzymes and Toxins
A. CatalaseStaphylococci produce catalase, which converts H2O2 into water and oxygen. The catalase test differentiates the staphylococci, Listeria monocytogenes, and Corynebacterium spp. are catalase-positive, from Streptococcus and Enterococcus, which are negative .
B. Coagulase and Clumping Factor
S aureus produces an extracellular coagulase, an enzyme like protein that clots oxalated or citrated plasma. Coagulase may deposit fibrin on the surface of staphylococci, changing their ingestion by phagocytic cells or their destruction within such cells.
Clumping factor is cell wall bound and that is responsible for adherence of the organisms to fibrinogen and fibrin.
When mixed with plasma, S aureus forms clumps. Clumping factor is distinct from coagulase.
Hemolysins
S aureus possesses four hemolysins.1- α-Hemolysin is a heterogeneous protein that acts on a broad spectrum of eukaryotic cell membranes.
2- The β-toxin degrades sphingomyelin and therefore is toxic for many kinds of cells, including human RBC.
3-The γ-hemolysin is a leukocidin that lyses white blood cells.
4-The δ-toxin is heterogeneous, it disrupts biologic membranes and may have a role in S aureus diarrheal diseases.
Panton–Valentine Leukocidin
PVL is encoded on a mobile phage. It can kill white blood cells of humans and rabbits.Exfoliative Toxins
These epidermolytic toxins of S aureus are two distinct proteins of the same molecular weight.
Exfoliative toxin A is encoded by eta located on a phage and is heat stable. Exfoliative toxin B is plasmid mediated and heat labile. These epidermolytic toxins yield the generalized desquamation of the staphylococcal scalded skin syndrome (SSSS) by dissolving the mucopolysaccharide matrix of the epidermis. The toxins are superantigens.
Toxic Shock Syndrome Toxin
Most S aureus strains isolated from patients with toxic shock syndrome produce a toxin called toxic shock syndrome toxin-1 (TSST-1). TSST-1 is the prototypical superantigen. The gene for TSST-1 is found in about 20% of S aureus isolates, including MRSA.Enterotoxins
There are 15 enterotoxins (A–E, G–P) that, similar to TSST-1, are superantigens. Approximately 50% of S aureus strains can produce one or more of them. The enterotoxins are heat stable and resistant to the action of gut enzymes. Important causes of food poisoning, enterotoxins are produced when S aureus grows in carbohydrate and protein foods.Other Enzymes
Other enzymes produced by staphylococci include a hyaluronidase, or spreading factor—a staphylokinase resulting in fibrinolysis but acting much more slowly than streptokinase, proteinases, lipases, and β-lactamase.
Table. Virulence Factors of Staphylococcus aureus
Product
Effect
Capsule
Inhibits phagocytosis
Coagulase
May block progress of leukocytes into infected area by producing clots in the surrounding capillaries
Exfoliative
Separates layers of epidermis, causing scalded skin syndrome
Hyaluronidase
Breaks down hyaluronic acid component of tissue, thereby promoting extension of infection
Leukocidin
Kills white blood cells by producing holes in their cytoplasmic membrane
Lipase
Breaks down fats by hydrolyzing the bond between glycerol and fatty acids
Protein A
Binds to Fc portion of antibody, inhibiting phagocytosis (blocks attachment to Fc receptors on white blood cells)
Toxic shock syndrome toxin
Causes rash, diarrhea, and shock
Pathogenesis
• Staphylococci, S. epidermidis, are members of the normal microbiota of the human skin and respiratory and gastrointestinal tracts.• Nasal carriage of S aureus occurs in 20–50% of humans. Staphylococci are also found regularly on clothing, bed linens, and other fomites in human environments.
• The pathogenic capacity of a given strain of S aureus is the combined effect of extracellular factors and toxins together with the invasive properties of the strain.
• At one end of the disease spectrum is staphylococcal food poisoning, attributable solely to the ingestion of preformed enterotoxin
• Pathogenic, invasive S aureus produces coagulase and tends to produce a yellow pigment and to be hemolytic.
• Nonpathogenic, noninvasive staphylococci such as S epidermidis are coagulase negative and tend to be non-hemolytic.
• S saprophyticus is typically non-pigmented, novobiocin resistant, and non-hemolytic; it causes urinary tract infections (UTI) in young women.
Pathology
• The prototype of a staphylococcal lesion is the furuncle or other localized abscess.furuncle caused by S. aureus
abscess caused by S. aureus
• Focal suppuration (abscess) is typical of staphylococcal infection. From any one focus, organisms may spread via the lymphatics and bloodstream to other parts of the body.
• In osteomyelitis, the primary focus of S aureus growth is typically in a terminal blood vessel of the metaphysis of a long bone, leading to necrosis of bone and chronic suppuration.
• S aureus may cause pneumonia, meningitis, endocarditis, or sepsis with suppuration in any organ.
• Staphylococci of low invasiveness are involved in many skin infections (eg, acne, or impetigo).
• Staphylococci also cause disease through the elaboration of toxins without apparent invasive infection. scalded skin syndrome, is caused by the production of exfoliative toxins.
• Toxic shock syndrome is associated with TSST-1.
Staphylococcal Scalded Skin Syndrome (SSSS) A toxin called exfoliatin, produced by strains of Staphylococcus aureus, causes the outer layer of skin to separate.
Clinical Findings
1-Localized skin infections: The most common S. aureus infections are small, superficial abscesses involving hair follicles (folliculitis) or sweat or sebaceous glands.• Subcutaneous abscesses called furuncles (boils).
• Carbuncles are larger, deeper, multiloculated skin infections that can lead to bacteremia and require antibiotic therapy.
• Impetigo is usually a localized, superficial, spreading skin lesion generally seen in children. It can be caused by S. aureus, although more commonly by Streptococcus pyogenes, or both organisms together.
furuncles
hair follicles (folliculitis)
2.Deep, localized infections: These may be metastatic from superficial infections or skin carriage, or may result from trauma. S. aureus is the most common cause of acute and chronic infection of bone marrow.
3. Acute endocarditis, generally associated with intravenous drug abuse, is caused by injection of contaminated preparations or by needles contaminated with S. aureus.
S. aureus also colonizes the skin around the injection site, and if the skin is not sterilized before injection, the bacteria can be introduced into soft tissues and the bloodstream, even when a sterilized needle is used.
4- Septicemia is a generalized infection with bacteremia.
5- Pneumonia: S. aureus is a cause of severe, necrotizing pneumonia6- Nosocomial infections: S. aureus is one of the most common causes of hospital-acquired infections, often of wounds (surgical) or bacteremia associated with catheters. Progression to septicemia is often a terminal event.
7-Toxinoses are diseases caused by the action of a toxin, frequently when the organism that secreted the toxin is undetectable. Toxinoses caused by S. aureus include:
*Toxic shock syndrome, which results in high fever, rash (resembling a sunburn, with diffuse erythema followed by desquamation), vomiting, diarrhea, hypotension, and multi-organ involvement (especially renal, and/or hepatic damage).
Staphylococcal scalded skin syndrome
*Staphylococcal gastroenteritis is caused by ingestion of food contaminated with enterotoxin-producing S. aureus. Often contaminated by a food-handler, these foods tend to be protein-rich (for example, egg salad, cream pastry) and improperly refrigerated. Symptoms, such as nausea, vomiting, and diarrhea, are acute following a short incubation period (1–8 hours). There is no fever.
Diagnostic Laboratory Tests
SpecimensSurface swab pus or aspirate from an abscess, blood, nasotracheal aspirate, sputum, or spinal fluid for culture, depending on the localization of the process.
Smears
Typical staphylococci appear as gram-positive cocci in clusters in Gram-stained smears of pus or sputum. It is not possible to distinguish non-pathogenic (S epidermidis) from the pathogenic S aureus organisms on smears.
Culture
Specimens planted on blood agar plates give rise to typical colonies in 18 hours at 37°C, but hemolysis and pigment production may not occur until several days later and are optimal at room temperature.S aureus but no other staphylococci ferment mannitol.
Specimens contaminated with a mixed microbiota can be cultured on media containing 7.5% NaCl; the salt inhibits most other normal microbiota, but not S aureus.
Catalase Test
This test is used to detect the presence of cytochrome oxidase enzymes.A drop of 3% H2O2 solution is placed on a slide, and a small amount of the bacterial growth is placed in the solution. The formation of bubbles (the release of oxygen) indicates a positive test result.
Coagulase Test
Citrated rabbit (or human) plasma diluted 1:5 is mixed with an equal volume of broth culture or growth from colonies on agar and incubated at 37°C. A tube of plasma mixed with sterile broth is included as a control. If clots form in 1–4 hours, the test result is positive.Serologic and Typing Tests
Serologic tests for diagnosis of S aureus infections have little practical value. Molecular typing techniques have been used to document the spread of epidemic disease-producing clones of S aureus.Treatment
• The multiple skin infections (acne, furunculosis) occur most often in adolescents. Tetracyclines are used for long-term treatment.• Abscesses and other closed suppurating lesions are treated by drainage, which is essential, and antimicrobial therapy.
• Bacteremia, endocarditis, pneumonia, and other severe infections caused by S aureus require prolonged intravenous therapy with a β-lactamase-resistant penicillin. Vancomycin is often reserved for use with nafcillin-resistant staphylococci.
• Alternative agents for the treatment of MRSA bacteremia and endocarditis include newer antimicrobials such as daptomycin.
• S epidermidis is more often resistant to antimicrobial drugs than is S aureus; approximately 75% of S epidermidis strains are nafcillin resistant. dalbavancin.